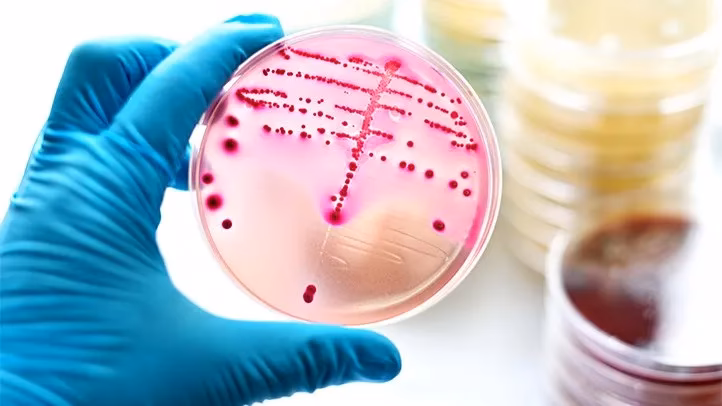
What is a streptococcus Berry?

17/08/2015
Streptokokker er en type bakterie, som de fleste af os støder på i løbet af livet. Navnet, der stammer fra græsk og betyder "snoet bær", beskriver meget præcist deres udseende under et mikroskop: runde celler, der ligger i kæder som perler på en snor. Selvom mange arter af streptokokker er harmløse og en naturlig del af vores krops bakterieflora i munden, tarmen og på huden, er der andre, som er berygtede for at forårsage en lang række sygdomme. Fra en simpel halsbetændelse til livstruende tilstande er det afgørende at forstå denne mangfoldige bakteriegruppe for at kunne genkende symptomerne og vide, hvornår man skal søge lægehjælp.
Hvad er Streptokokker helt præcist?
Streptokokker er en slægt af Gram-positive, kugleformede bakterier. At de er "Gram-positive" er en mikrobiologisk klassificering, der refererer til, hvordan de reagerer på en bestemt farvningsmetode (Gram-farvning), hvilket skyldes opbygningen af deres cellevæg. De er typisk ubevægelige og findes overalt i naturen, men er især kendt for deres forhold til mennesker og dyr. Nogle streptokok-arter spiller en positiv rolle, for eksempel i produktionen af mejeriprodukter som yoghurt og ost, mens andre er patogene, hvilket betyder, at de kan forårsage sygdom.
Man inddeler ofte streptokokker i grupper baseret på deres evne til at nedbryde røde blodlegemer, en proces kaldet hæmolyse. Denne klassifikation er vigtig for læger, da den kan give et fingerpeg om, hvor farlig en bestemt type streptokok kan være.
Klassifikation af Streptokokker
For at forstå de forskellige sygdomme er det nyttigt at kende til de primære grupper:
- Beta-hæmolytiske streptokokker: Disse er kendt for at forårsage en fuldstændig nedbrydning af røde blodlegemer. Den mest berygtede i denne kategori er Gruppe A Streptokok (GAS), videnskabeligt kendt som Streptococcus pyogenes. Denne type er ansvarlig for de fleste velkendte streptokokinfektioner. Gruppe B Streptokokker (GBS) er også i denne kategori og kan forårsage alvorlig sygdom hos nyfødte.
- Alfa-hæmolytiske streptokokker: Disse forårsager en ufuldstændig nedbrydning af røde blodlegemer. Gruppen inkluderer Streptococcus pneumoniae, en hyppig årsag til lungebetændelse, og Viridans-streptokokker, som er en del af den normale mundflora, men kan forårsage hjerteklapbetændelse (endokarditis), hvis de kommer ind i blodbanen.
- Gamma-hæmolytiske streptokokker: Disse har ingen hæmolytisk aktivitet. Mange af disse er harmløse, men gruppen inkluderer Enterokokker (tidligere kendt som Gruppe D streptokokker), som kan forårsage urinvejsinfektioner og andre hospitalserhvervede infektioner.
Sygdomme forårsaget af Gruppe A Streptokokker (GAS)
Når folk taler om "streptokokker" i daglig tale, refererer de næsten altid til infektioner forårsaget af Gruppe A Streptokokker. Disse er meget smitsomme og kan føre til en række forskellige sygdomme, fra milde til livstruende.
Almindelige Infektioner
- Halsbetændelse (Faryngitis): Dette er den mest kendte streptokokinfektion. Symptomerne inkluderer pludselig og kraftig ondt i halsen, synkesmerter, feber, hævede og ømme lymfeknuder på halsen, og ofte hvide pletter eller pus på mandlerne. Til forskel fra en virus-halsbetændelse er hoste og løbende næse typisk fraværende.
- Børnesår (Impetigo): En overfladisk hudinfektion, der er meget smitsom og især almindelig hos børn. Den viser sig som røde sår eller blærer, der brister og efterlader en karakteristisk gylden, honningfarvet skorpe.
- Skarlagensfeber (Scarlatina): Dette er i bund og grund en halsbetændelse ledsaget af et karakteristisk udslæt. Udslættet føles som sandpapir og starter typisk på brystet og i nakken, før det spreder sig til resten af kroppen. Tungen kan også blive rød og hævet, en tilstand kendt som "jordbærtunge".
- Rosen (Erysipelas): En infektion i de øvre lag af huden, som viser sig som et velafgrænset, rødt, hævet og smertende område. Ofte ledsaget af feber og almen utilpashed.
Alvorlige og Invasive Infektioner
I sjældne tilfælde kan Gruppe A streptokokker trænge dybere ind i kroppen og forårsage livstruende tilstande. Dette kaldes invasiv GAS-sygdom.
- Nekrotiserende fasciitis: Også kendt som den "kødædende bakterie". Dette er en ekstremt alvorlig og hurtigt spredende infektion i de dybe lag af hud og væv. Den forårsager intens smerte, hævelse og vævsdød. Tilstanden kræver øjeblikkelig kirurgisk indgriben og aggressiv antibiotikabehandling.
- Streptokok Toksisk Shock Syndrom (STSS): En hurtigt progredierende og livstruende tilstand, hvor bakterierne frigiver toksiner i blodbanen. Dette fører til et pludseligt blodtryksfald (shock) og svigt af flere organer.
- Barselsfeber (Puerperal sepsis): En historisk frygtet infektion, der kan opstå i livmoderen efter en fødsel. Takket være moderne hygiejne og antibiotika er den i dag sjælden i den vestlige verden.
Diagnose og Behandling
En præcis diagnose er afgørende for korrekt behandling. Ved mistanke om halsbetændelse vil en læge ofte tage en podning fra halsen. En hurtigtest (Strep A-test) kan give svar på få minutter. Hvis den er negativ, men mistanken stadig er stor, kan podningen sendes til dyrkning i et laboratorium for et mere sikkert svar.
Behandlingen for de fleste Gruppe A streptokok-infektioner er antibiotika, typisk penicillin. Det er ekstremt vigtigt at fuldføre hele antibiotikakuren, selvom man føler sig bedre tilpas efter et par dage. Dette sikrer, at alle bakterier er udryddet og reducerer risikoen for at udvikle alvorlige komplikationer som gigtfeber.
| Symptom | Streptokok-halsbetændelse | Viral halsbetændelse (forkølelse) |
|---|---|---|
| Smerteintensitet | Moderat til svær, pludselig start | Mild til moderat, gradvis start |
| Feber | Ofte høj (over 38.5°C) | Typisk lav eller ingen feber |
| Mandler | Røde, hævede, ofte med hvide pletter | Kan være let røde |
| Lymfeknuder | Hævede og ømme på forsiden af halsen | Kan være let hævede |
| Andre symptomer | Hovedpine, mavesmerter, kvalme | Hoste, løbende næse, hæshed |
Forebyggelse er Nøglen
Da streptokokker spredes via dråbesmitte (hoste, nys) og direkte kontakt, er god hygiejne den bedste måde at forebygge infektion på.
- Vask hænder ofte: Brug sæbe og vand, især efter at have hostet, nyst eller pudset næse.
- Undgå at dele: Del ikke drikkeglas, bestik, eller personlige genstande som tandbørster.
- Dæk mund og næse: Brug et engangslommetørklæde eller din albue, når du hoster eller nyser.
- Bliv hjemme: Hvis du er diagnosticeret med en streptokokinfektion, så bliv hjemme fra arbejde eller skole i mindst 24 timer efter påbegyndt antibiotikabehandling for at undgå at smitte andre.
Ofte Stillede Spørgsmål
Er streptokokker altid farlige?
Nej, absolut ikke. Mange streptokok-arter er en harmløs del af vores normale bakterieflora. Det er primært specifikke grupper som Gruppe A og Gruppe B streptokokker samt Streptococcus pneumoniae, der er kendt for at forårsage sygdom.
Hvorfor er det vigtigt at behandle halsbetændelse med antibiotika?
Udover at lindre symptomerne og reducere smitteperioden er hovedårsagen til at behandle streptokok-halsbetændelse at forhindre sjældne, men alvorlige senfølger. Den mest frygtede er gigtfeber (reumatisk feber), en autoimmun reaktion, der kan opstå uger efter infektionen og forårsage permanent skade på hjerteklapperne.
Kan man få streptokokker mere end én gang?
Ja. Der findes mange forskellige stammer af Gruppe A streptokokker. At have haft en infektion med én stamme giver ikke immunitet mod de andre. Derfor kan man godt få halsbetændelse forårsaget af streptokokker flere gange i sit liv.
Hvad er Gruppe B Streptokokker (GBS)?
Gruppe B streptokokker (GBS) er en type bakterie, der normalt findes i tarmen og skeden hos omkring 15-25% af alle raske, voksne kvinder. Det er normalt harmløst for kvinden, men kan overføres til barnet under fødslen og forårsage alvorlig sygdom som blodforgiftning (sepsis) og meningitis hos den nyfødte. Gravide kvinder bliver derfor ofte screenet for GBS.
Hvis du vil læse andre artikler, der ligner Streptokokker: En guide til bakterien, kan du besøge kategorien Sundhed.

